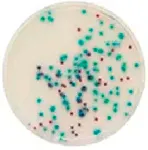
CHROMagar Pseudomonas. Chromogenic culture medium for the detection and enumeration of Pseudomonas.

CHROMagar™ Pseudomonas
Chromogenic dehydrated medium for isolation and detection of Pseudomonas spp. Applicable to the membrane filtration technique.

Chromogenic dehydrated medium for isolation and detection of Pseudomonas spp. Applicable to the membrane filtration technique.

Features
Presentation
30 plates of 55mm Ø Type of packaging
filtration plates stack
30 plates of 55mm Ø Type of packaging
filtration plates stack

 Rest of the World
Rest of the World